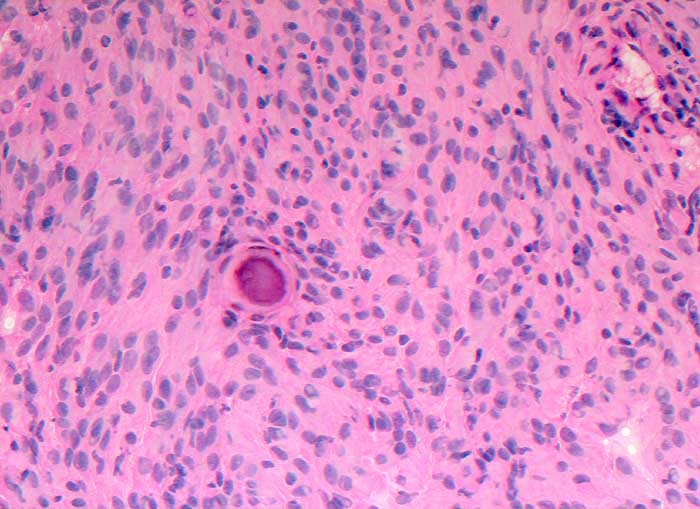

PathoPic – image database / PathoPic ID 5630 - Meningeom
de
Diagnose
Meningeom
Diagnose Gruppe
benigner Tumor
Topographie
Rückenmark
Topographie Gruppe
Nervensystem
Beschreibung
Im Schnellschnitt sind psammomatöse Verkalkungen und meningotheliale Zellen ohne Atypien erkennbar.
Klinik
Spinaler Tumor Th 12.
Kommentar
Zytologische Diagnose: Meningeom. Am ehesten handelt es sich um einen transitionalen Typ mit häufigem Nachweis von Wirbelbildungen und Psammomkörperchen.
Bilder Typ
Schnellschnitt
Vergrösserung
200
Alter
39
Geschlecht
unbekannt
Datum
Ersteintrag: 26.12.2002
Update: 04.02.2024